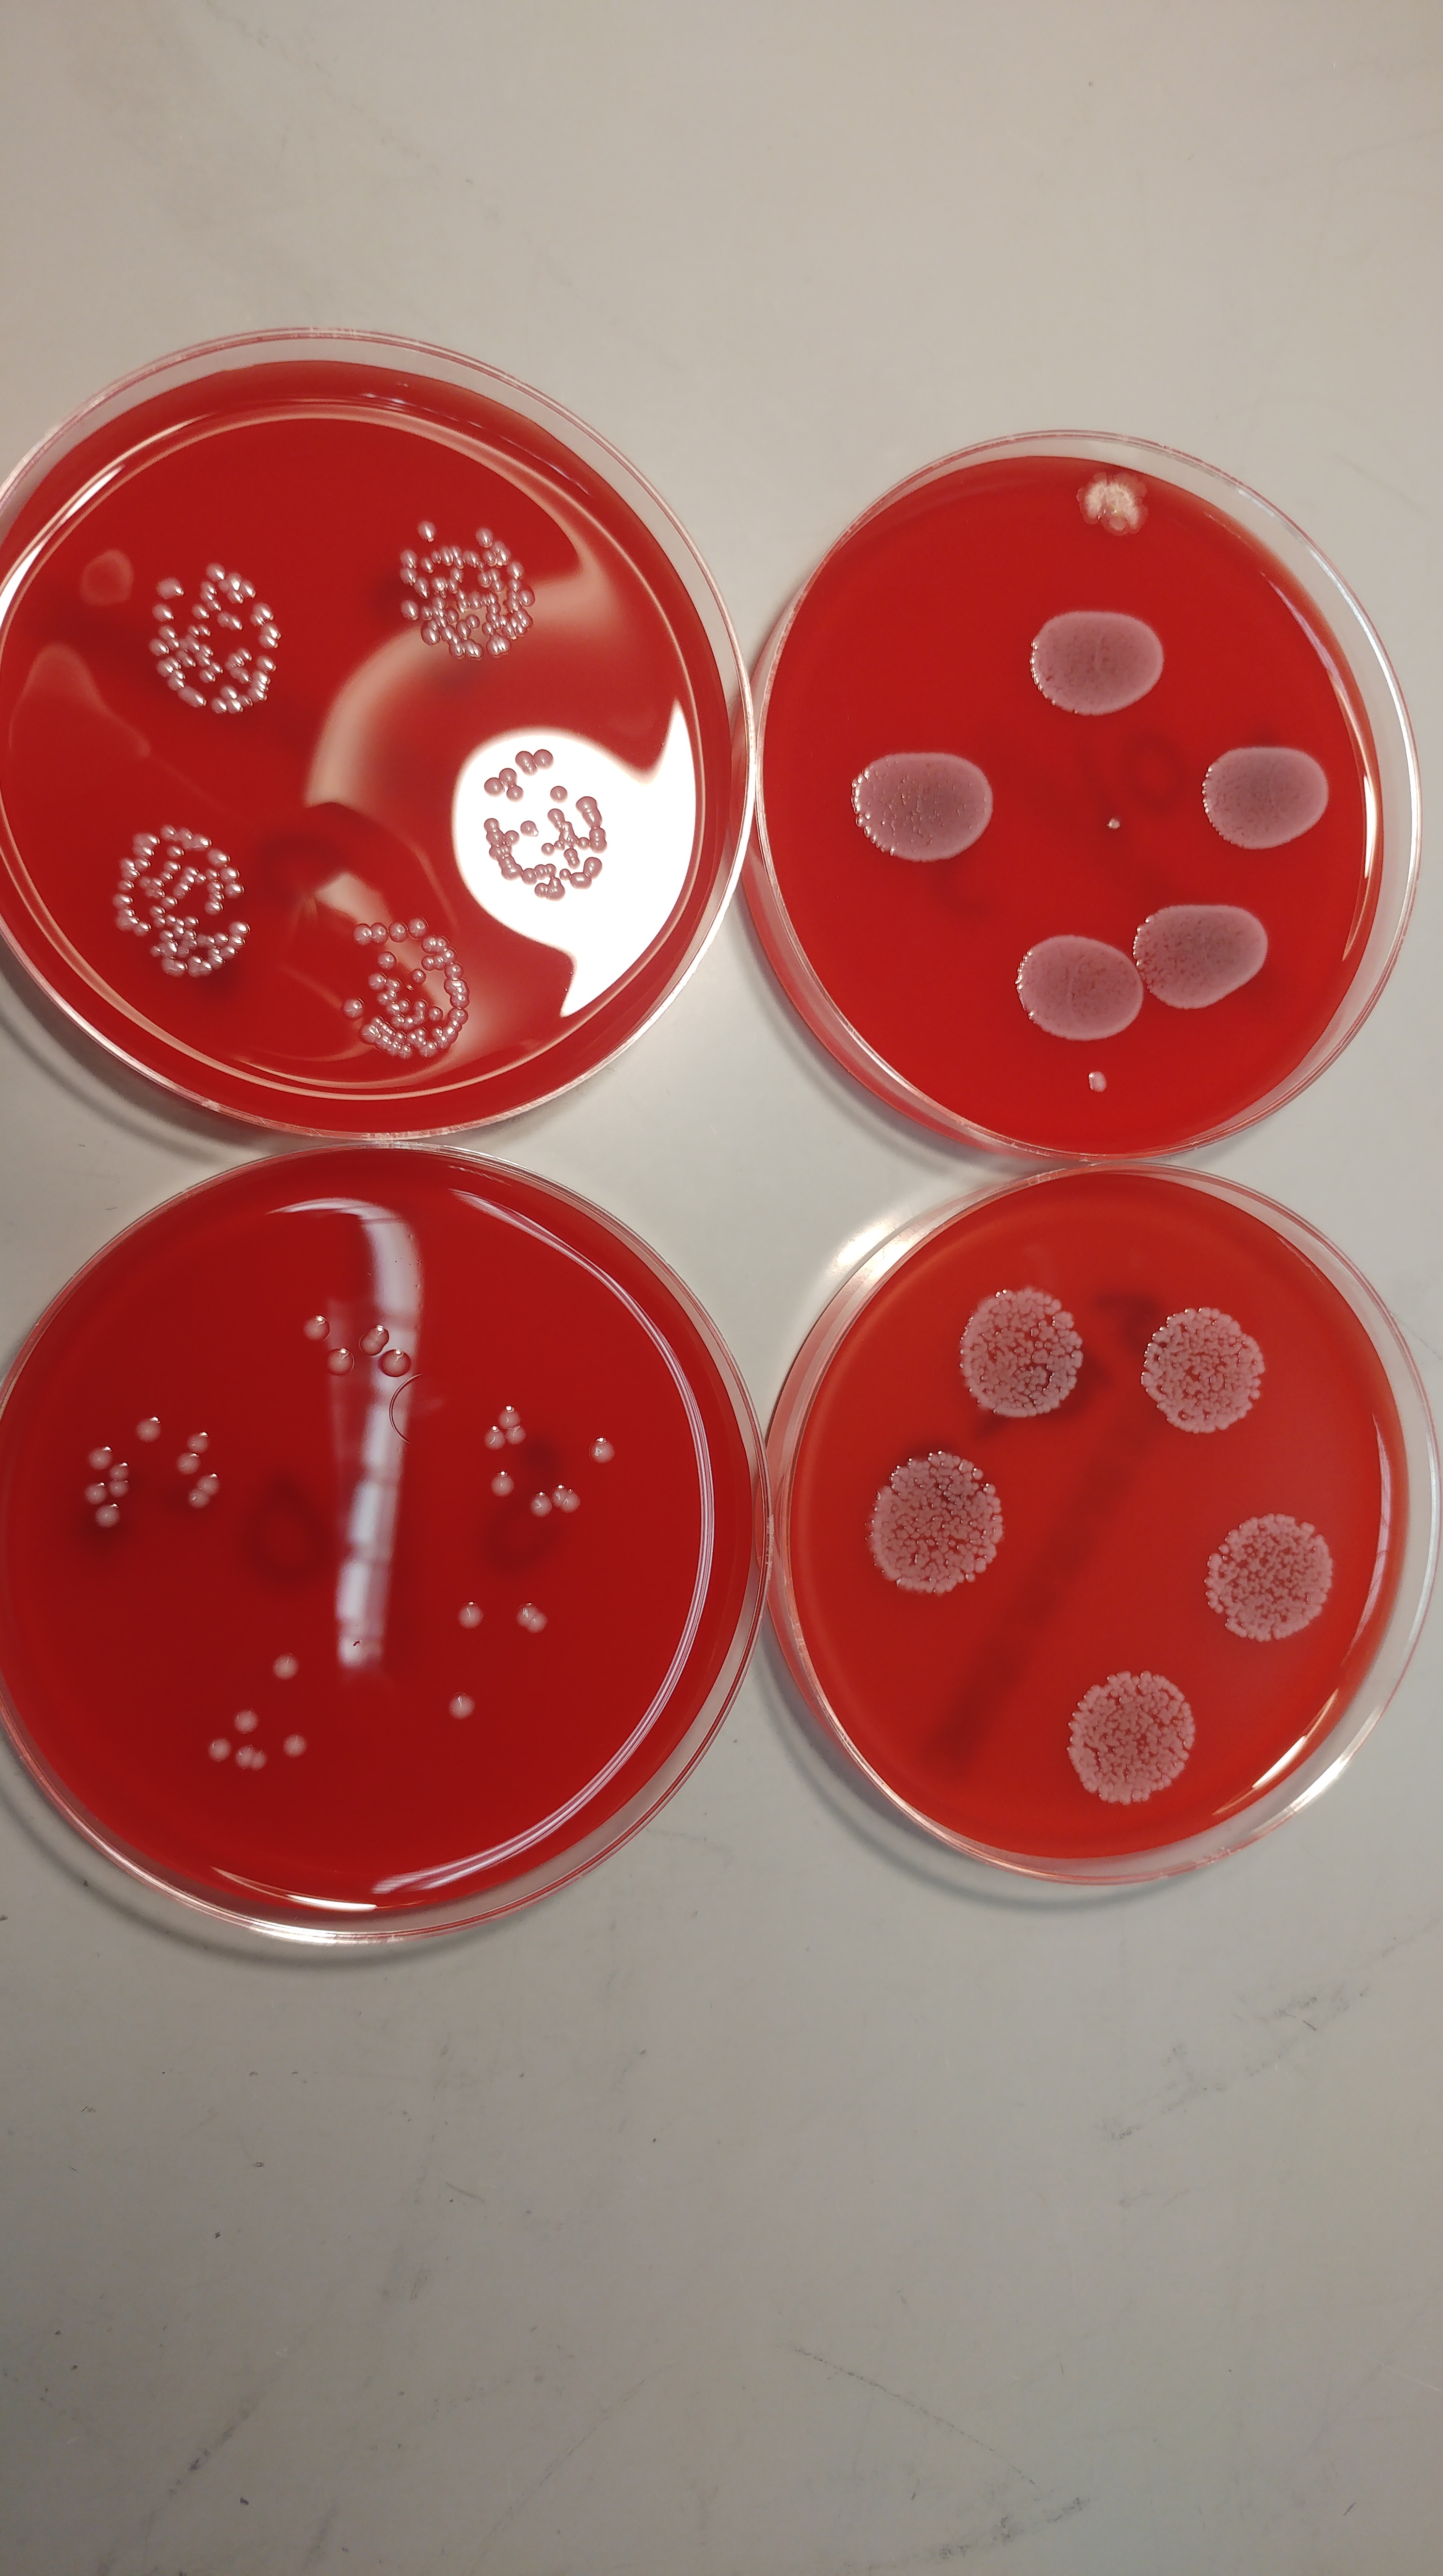

Links to Publication Lists
https://orcid.org/0000-0001-7534-3196
Publications on Surfaces and Cleaning
Two-step or one-step – are all methods for neonatal incubator decontamination equal
Samuel Watkin, Helen Dunn, Derren Ready, Kate Rennie, Anna Soares, Lena Ciric, Elaine Cloutman-Green. Journal of Hospital Infection (2024)
H. Rickard, E. Cloutman-Green, L. Ciric. Journal of Hospital Infection (2024) 151: 84-91
Trends in viable microbial bioburden on surfaces within a paediatric bone marrow transplant unit
S. Watkin, E. Cloutman-Green, M. Kiernan, L. Ciric. Journal of Hospital Infection (2024) 148: 167-177
Rawlinson S, Asadi F, Saraqi H, Child B, Ciric L, Cloutman-Green E. IPIP 2020;2:4 December 2020
COVID-19 pandemic – let’s not forget surfaces
Rawlinson S, Ciric L, Cloutman-Green E. JHI; 2020:May 19
Surface Sampling Within a Pediatric Ward – How Multiple Factors Affect Cleaning Efficacy
Rawlinson S, Cloutman-Green E, Asadi F, Ciric L. AJIC 2020:July 48(7):740-745
Rawlinson S, Ciric L, Cloutman-Green E. J Hosp Infect. 2019:December 103(4):363-374
Cloutman-Green E, Canales M, Pankhurst L, Evenor T, Malone D, Klein N, Ciric L, Hartley JC. Am J Infect Control. 2015 Sep; 43(9): 997-999.
Routine Monitoring of Adenovirus and Norovirus within the Healthcare Environment
Cloutman-Green E, Pankhurst L, Canales M, D’Arcy N, JC Hartley. Am J Infect Control. 2014 Nov;42(11):1229-32.
How Clean is Clean – Is a New Microbiological Standard Required?
Cloutman-Green E, D’Arcy N, Spratt DA, Hartley JC and Klein N. Am J Infect Control. 2014 Sep;42(9):1002-3.
Environmental viral contamination in a paediatric hospital: implications for infection control
D’Arcy N, Cloutman-Green E, Spratt DA, Hartley JC and Klein N. Am J Infect Control. 2014 Aug;42(8):856-60.
The important role of sink location in hand washing compliance and microbial sink contamination
Cloutman-Green E, Kalaycioglu O, Wojani H, Hartley JC, Guillas S, Malone D, Gant V, Grey C, Klein N. Am J Infect Control. 2014. Vol. 42(5):554-555
D’Arcy N, Cloutman-Green E, Lai K, Margaritis D, Klein N, Spratt DA. Indoor and Built Environment, May 2014; 23(3):467-473
Gaudart J, Cloutman-Green E, Guillas S, D’Arcy N, Hartley JC, Gant V, Klein N. PLoS One. 2013 Sep 19;8(9):e76249.
Wojgani H, Kehsa C, Cloutman-Green E, Gray C, Gant V, Klein N. PLoS One. 2012;7(10):e40171.
Moore G, Ali S, Cloutman-Green EA, Bradley CR, Wilkinson MA, Hartley JC, Fraise AP, Wilson AP. BMC Infect Dis. 2012 Aug 3;12:174

Publications on Transmission and Prevention of Healthcare Associated Infection
Pandemic preparedness: is the UK ready for a pandemic that affects children?
O’Callaghan C, Cloutman-Green E, Brierley J. BMJ. 2023 Nov 28;383:2804
Rickard H, Watkin S, Baldwin N, De Souza A, Ciric L, Cloutman-Green E. Infection Prevention in Practice 2023 Nov 5(4)
Watkin S, Ciric L, Kiernan M, Cloutman-Green E. J Hosp Infect. 2023 Mar 20:S0195-670.
Agreiter I, Kozijn A E 2, Bakunina K, Averbuch D, Stringer J, Hutt D, Mikulska M, Bögel T N, Canesi M, Cloutman-Green E, Bosman P V, Gil L, Liptrott S J, Murray J, Styczynski J; Nurses Group and Infectious Diseases Working Party of EBMT. Bone Marrow Transplant 2021 Jun;56(6):1433-1440
Who decides what’s relevant? Factors driving publication on clinically significant organisms
Rawlinson S, Ciric L, Cloutman-Green E. Who decides what’s relevant? Factors driving publication on clinically significant organisms. IPIP June 2020:2(2)
Cloutman-Green E, Barbosa VL, Jimenez D, Wong D, Dunn H, Needham B, Ciric L, Hartley JC. AJIC 2019 July. 47(7):761-766
Biochemical and microbial contamination of surgical devices: A quantitative analysis
Cloutman-Green E, Canales M, Qizhi Zhou, Ciric L, Hartley JC, McDonnell G. Am J Infect Control. 2015 Jun;43(6):659-61.
Patel P, Tuke P, Tettmar K, Cloutman-Green E, Hartley J, Klein N, Veys P, Tedder R. Vox Sanguinis. 2015 Jul;109(1):95-7.
Critical evaluation of ninhydrin for monitoring surgical instrument decontamination
Nayuni NK, Cloutman-Green E, Hollis M, Hartley J, Martin S, Perrett D. J Hosp Infect. 2013 Jun;84(2):97-102
Pankhurst, L. J., Lai, K. M., Cloutman-Green, E. A. and Hartley, J. C. Indoor and Built Environment, June 2012; vol. 21, 3: pp. 381-391
Mark Bishay, Giuseppe Retrosi, Venetia Horn, Elaine Cloutman-Green, Kathryn Harris, Paolo De Coppi, Nigel Klein, Simon Eaton, Agostino Pierro. European Journal of Paediatric Surgery. 2012 Feb;22(1):50-3
Mark Bishay, Giuseppe Retrosi, Venetia Horn, Elaine Cloutman-Green, Kathryn Harris, Paolo De Coppi, Nigel Klein, Simon Eaton, Agostino Pierro. Journal of Pediatric Surgery (2011) 46, 1064–1069

Publications on the Use of Nanoparticles for Infection Prevention
Synergistic Antibacterial Effects of Metallic Nanoparticle Combinations
Bankier, C, Matharu, R. K, Cheong, Y.K, Ren, G. G, Cloutman-Green, E, Ciric, L. Nature Scientific Reports 2019. 9:16074
Bankier C, Cheong Y, Mahalingam S, Edirisinghe M, Ren G, Cloutman-Green E, Ciric L. PLoS One. 2018 Feb 1;13(2):e0192093.
Cheong YK, Calvo-Castro J, Ciric L, Edirisinghe M, Cloutman-Green E, Illangakoon UE, Kang Q, Mahalingam S, Matharu RK, Wilson RM, Ren G. Nanomaterials (Basel). 2017 Jun 23;7(7).
Gyrospun antimicrobial nanoparticle loaded fibrous polymeric filters
Eranka Illangakoon, Suntharavathanan Mahalingam, Katherine Wang, Y. K.Cheong, Melisa Canales, Guogang Ren, Elaine Cloutman-Green, Mohan Edirisinghe, Lena Ciric. Materials Science and Engineering: C. Volume 74, 1 May 2017, Pages 315–324.
Publications on the Characterisation and Detection of Pathogens
Clostridioides difficile detection and infection in children: are they just small adults?
Watkin S, Yongblah F, Burton J, Hartley JC, Cloutman-Green E. J Med Microbiol. 2024 Mar;73(3).
Luoma, J, Adubra, L, Alber, D, Cloutman-Green E et al. Trials 24, 733 (2023)
Adubra, L., Alber, D., Ashorn, P. Cloutman-Green E et al. Trials 24, 5 (2023)
Evolutionary and functional history of the Escherichia coli K1 capsule
Arredondo-Alonso, S., Blundell-Hunter, G., Fu, Z. Cloutman-Green E et al. Nat Commun 14, 3294 (2023)
Staphylococcus capitis: Review of Its Role in Infections and Outbreaks
Heath V, Cloutman-Green E, Watkin S, Karlikowska M, Ready D, Hatcher J, Pearce-Smith N, Brown C, Demirjian A. Antibiotics (Basel). 2023 Mar 29;12(4):669.
Kite KA, Loomba S, Elliott TJ, Yongblah F, Lightbown SL, Doyle TJ, Gates L, Alber D, Downey GA, McCurdy MT, Hill JA, Super M, Ingber DE, Klein N, Cloutman-Green E. PLoS One 2022 Nov 22;17(11)
Alber D, Haidara FC, Luoma J, Adubra L, Ashorn P, Ashorn U, Badji H, Cloutman-Green E, Diallo F, Ihamuotila R, Klein N, Martell O, Onwuchekwa UU, Samaké O, Sow SO, Traore A, Wilson K, Ducker C, Fan YM. BMJ Open 2022 Jun 16;12(6)
Vaitkute G, Panic G, Alber DG, Faizura-Yeop I, Cloutman-Green E, Swann J, Veys P, Standing JF, Klein N, Bajaj-Elliott M. Microbiome 2022 Jun 10;10(1):89
Gärtner K, Meleke H, Kamdolozi M, Chaima D, Samikwa L, Paynter M, Nyang’Wa MN, Cloutman-Green E, Nastouli E, Klein N, Nyirenda T. A. Virol J 2022 May 2;19(1):77
Olivier Touzelet, Lindsay Broadbent, Stuart D. Armstrong, Waleed Aljabr, Elaine Cloutman-Green, Ultan F. Power, Julian A. Hiscox. Molecular & Cellular Proteomics 2020, 19 (5) 793-807
High Resolution Analysis of Respiratory Syncytial Virus Infection In Vivo
Aljabr W, Armstrong S, Rickett NY, Pollakis G, Touzelet O, Cloutman-Green E, et al. Viruses. 2019;11:926
Farrer R, Ford CB, Rhodes J, Delorey T, May R, Fisher MC, Cloutman-Green E, Balloux F, Cuomo CA. mSphere Oct 2018, 3 (5)
Houldcroft CJ, Roy S, Morfopoulou S, Margetts BK, Depledge DP, Cudini J, Shah D, Brown JR, Yara Romero E, Williams R, Cloutman-Green E, Rao K, Standing JF, Hartley J, Breuer J. J Infect Dis. 2018:October 8(15):1261–1271.
Voets GM, Leverstein-van Hall MA, Kolbe-Busch S, van der Zande A, Church D, Kaase M, Grisold A, Upton M, Cloutman-Green E, Cantón R, Friedrich AW, Fluit AC; J Clin Microbiol. 2013 Dec;51(12):3944-9
Harris KA, Turner P, Green EA, Hartley JC. J Clin Microbiol. 2008 Aug;46(8):2751-8


[…] Publications […]
LikeLike
[…] Publications […]
LikeLike
[…] Publications […]
LikeLike